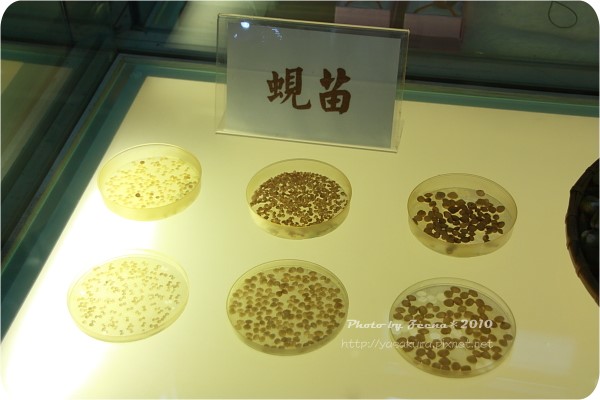
25.jpg 25.jpg

這天睡的比較晚,不過莫還是很早就起床了。
今天是行程是花蓮景點趴趴走8點大家準備好就告別蝴蝶谷。
開車前往第一個目的地:北回歸線標誌公園

這邊只是一個小小的景點,但是來的人還不少
全世界有北迴歸線經過的國家沒幾個阿

幸好今天的天公有作美,沒有下雨,但是還是陰陰的。

公園裡有很多介紹星體運轉等等的說明,大家在這邊逛一逛看一看

一定要把湯瑪士也拍進去

給你猜,小朋友在"噓"什麼?? 答案(請反白):有隻掛點的蜜蜂,他們以為蜜蜂睡著了,所以小小聲說話

第2個景點:花蓮糖廠

這邊也是很多人不過大家都搶停在員工宿舍那邊,我們則跟著遊覽車停到比較裡面工廠的地方。
看來這邊的名產是冰淇淋跟扁食。
買冰淇淋要買票耶第一次看到這種方式。

排隊買票後,再到旁邊的窗口領冰!!酷吧
超多人在吃冰的,就算天氣人也一樣很有人氣。

莫吃的是脆餅鮮奶冰淇淋,不錯吃,很濃郁的味道。
老公吃的是碗裝紅豆鮮奶冰淇淋,也滿好吃的。
不過價錢也不便宜。

一邊吃冰一邊看旁邊的牛車在繞圈圈,不過照像要20元耶偷偷拍!!!


吃完冰後,又接著跑去吃扁食,不過大家剛剛吃了冰有點小飽,只叫了4碗來分著吃。
都很大顆,味道也不錯就這樣解決的中餐

在糖廠附近逛一逛看一看



這些運糖的貨車都很老囉




來個大合照


第3站:立川漁場

這裡在7、8年前莫就有來過,那時候還沒有很有名,遊客也不多。
今天一看挖咧,超多人的,可能拜"蜆精"熱銷之賜吧。
來到這邊天空開始下起雨來!!

小小的場地塞滿了人在聽解說。
本來想說要下去撈蜆的,因為天冷外加下雨而"取消行程"。

不過還是有"勇者"下水去體驗一下


這次拍魚沒有失敗阿哈哈哈 (好狗運)

定時會有工作人員倒一些下去給遊客撿。
這邊有蛤利湯跟清炒的可以叫來吃,但是等的人超級多足足等了有半個小時以上吧。
別人家的小狗,很可愛吧,腿短短的

等不及的老公買了一些烤香腸來吃,小朋友每個人都先吃了一條去。

在吃東西的同時雨越來越大了,只好打消繼續遊玩的計畫,準備北上回家囉,結束過年的旅遊。
